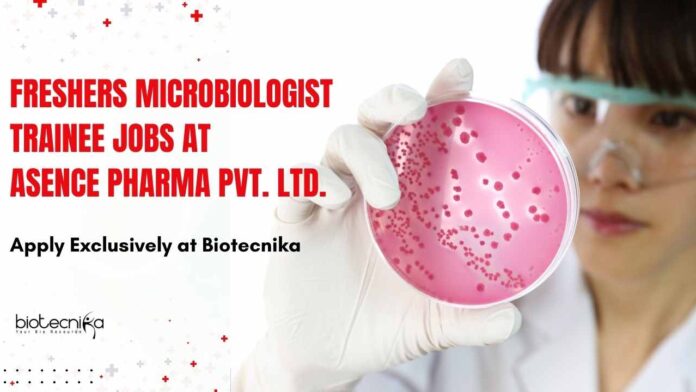

Freshers Microbiologist Trainee Jobs at Asence Pharma Pvt. Ltd., Apply Exclusively at Biotecnika
Company Name: Asence Pharma Pvt. Ltd.
Job Role: Microbiologist Trainee
Location: Ranoli, Vadodara
CTC: 1.5 LPA (During 2-3 months of internship), Post Completion – 3 to 3.5 LPA
Experience: Fresher (Only Candidates Based In Vadodara Should Apply)
Job Summary:
We are looking for a motivated and dynamic Microbiologist Trainee to join our team at Asence Pharma Pvt. Ltd., a leading API (Active Pharmaceutical Ingredient) pharmaceutical company. The ideal candidate will assist in microbiological testing, environmental monitoring, and quality assurance activities to support the production of high-quality pharmaceutical products in compliance with industry standards and regulatory guidelines.
Key Responsibilities:
- Assist in conducting microbiological testing of raw materials, in-process materials, and finished pharmaceutical products to ensure adherence to quality standards.
- Perform microbial analysis techniques, such as plate count, sterility testing, endotoxin testing, and microbial identification.
- Participate in environmental monitoring of manufacturing areas, ensuring compliance with GMP (Good Manufacturing Practices) and other regulatory requirements.
- Support the preparation and sterilization of microbiological media, reagents, and solutions.
- Document and maintain accurate records of microbiological testing and lab activities under GMP and other regulatory guidelines.
- Assist in stability studies and microbiological testing to evaluate product quality over time.
APPLY ONLINE HERE ((Only Candidates Based In Vadodara Should Apply))
Editor’s Note: Please ensure you are subscribed to the Biotecnika Times Newsletter and our YouTube channel to be notified of the latest industry news. Follow us on social media like Twitter, Telegram, Facebo